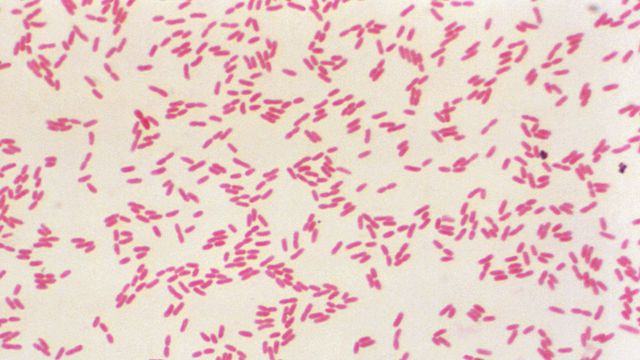
Gram-negative, rod-shaped, Burkholderia pseudomallei bacteria. under a microscope, relevant to vaccine research and development.

Trending News
News

News
Mosquito Blood Reveals Nearly All Local Wildlife
Researchers analyzed mosquito blood meals from a preserve and identified DNA from 86 vertebrate species. The results captured nearly all local biodiversity, from frogs to deer, showing mosquitoes could offer a fast, low-cost way to monitor wildlife.

News
Engineered Dendritic Cells Boost Cancer Immunotherapy
Engineering dendritic cells to better identify cancer cells and trigger precise immune responses may boost immunotherapy.

News
New Role for Gut Bacteria in Pregnancy Success
A preclinical study from Weill Cornell Medicine shows that beneficial gut microbes help prevent pregnancy loss by promoting immune tolerance to the fetus.

News
Genome Differences May Explain Why Some Antibody Drugs Fail
Common genetic variants can prevent antibody therapies from binding their targets, reducing treatment effectiveness. The study shows how small amino acid changes can block drug binding.

News
Ultra-Processed Diets Alter Gut Microbe Evolution
UCLA researchers found that gut bacteria are rapidly evolving in response to modern diets. Genes enabling digestion of industrial starches have spread quickly through microbial genomes via horizontal gene transfer.

News
Antibody-Specific AI Model Could Accelerate Therapeutic Discovery
Researchers developed an AI antibody model that accurately predicts heavy and light chain pairing, challenging long-held assumptions and advancing therapeutic design.

News
Gut Bacteria From Frogs Can Eliminate Tumors
Researchers have discovered that a bacterium isolated from the intestines of Japanese tree frogs possesses potent anticancer activity.

News
Harnessing Microbes To Promote Human Health
New open-access database highlights health-promoting microbes and natural compounds that support wellbeing beyond disease prevention.

News
Single Gut Microbe Found To Limit Weight Gain
A study finds that a single gut bacterium can lower blood sugar, reduce fat accumulation and limit weight gain in mice. The microbe produces fatty molecules that counter harmful metabolic effects of high-fat diets.

News
“Viruses Are So, So Clever” – But This Discovery Could Stop Them
UMBC scientists uncovered how enteroviruses initiate replication by assembling a conserved RNA–protein complex inside host cells. The team showed how viral and host proteins bind an RNA cloverleaf to control replication.
Advertisement